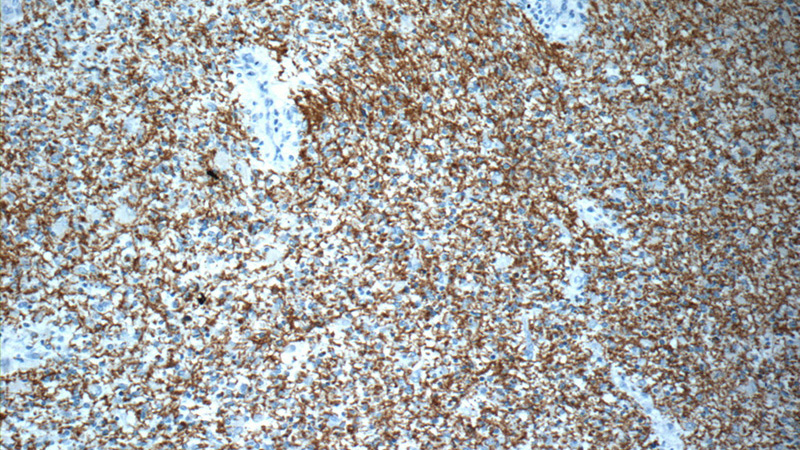
Immunohistochemistry of paraffin-embedded human gliomas slide using Catalog No:114775(ROBO3-Specific Antibody) at dilution of 1:50
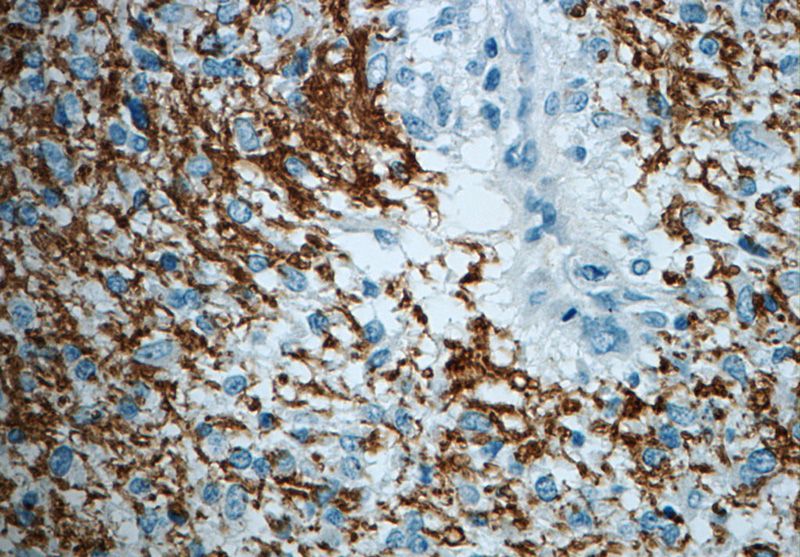
Immunohistochemistry of paraffin-embedded human gliomas slide using Catalog No:114775(ROBO3-Specific Antibody) at dilution of 1:50

-
Product Name
ROBO3-Specific antibody
- Documents
-
Description
ROBO3-Specific Rabbit Polyclonal antibody. Positive IHC detected in human gliomas tissue, human brain tissue. Positive WB detected in mouse brain tissue, SH-SY5Y cells. Observed molecular weight by Western-blot: 55kd
-
Tested applications
ELISA, WB, IHC
-
Species reactivity
Human,Mouse,Rat; other species not tested.
-
Alternative names
FLJ21044 antibody; HGPPS antibody; HGPS antibody; RBIG1 antibody; RIG1 antibody; ROBO3 antibody; Roundabout homolog 3 antibody; Roundabout like protein 3 antibody
-
Isotype
Rabbit IgG
-
Preparation
This antibody was obtained by immunization of Peptide (Accession Number: NM_022370). Purification method: Antigen affinity purified.
-
Clonality
Polyclonal
-
Formulation
PBS with 0.02% sodium azide and 50% glycerol pH 7.3.
-
Storage instructions
Store at -20℃. DO NOT ALIQUOT
-
Applications
Recommended Dilution:
WB: 1:200-1:2000
IHC: 1:20-1:200
-
Validations

mouse brain tissue were subjected to SDS PAGE followed by western blot with Catalog No:114775(ROBO3-Specific antibody) at dilution of 1:300
Immunohistochemistry of paraffin-embedded human gliomas slide using Catalog No:114775(ROBO3-Specific Antibody) at dilution of 1:50
Immunohistochemistry of paraffin-embedded human gliomas slide using Catalog No:114775(ROBO3-Specific Antibody) at dilution of 1:50
-
Background
ROBO3 belongs to the immunoglobulin superfamily and ROBO family. ROBO3 is thought to be involved during neural development in axonal navigation at the ventral midline of the neural tube. In spinal chord development it plays a role in guiding commissural axons probably by preventing premature sensitivity to Slit proteins thus inhibiting Slit signaling through ROBO1. It is required for hindbrain axon midline crossing. Defects in ROBO3 are a cause of familial horizontal gaze palsy with progressive scoliosis (HGPPS). Patients show a medulla where motor and sensory projections appear uncrossed. The antibody is specific to ROBO3.
Related Products / Services
Please note: All products are "FOR RESEARCH USE ONLY AND ARE NOT INTENDED FOR DIAGNOSTIC OR THERAPEUTIC USE"
